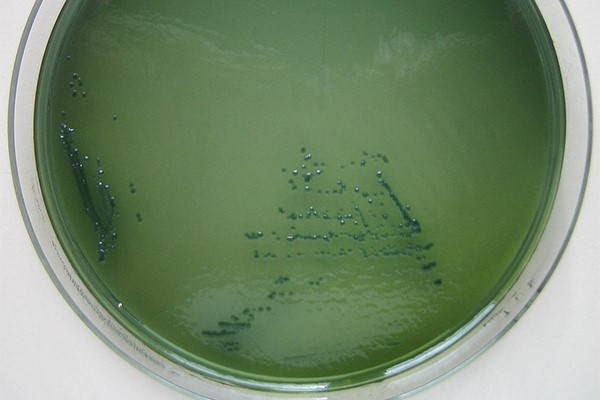
Các nhà nghiên cứu cho biết xét nghiệm nhanh vi khuẩn Vibrio parahaemolyticus (nhóm vi khuẩn Vibrio trong môi trường thạch như hình trên) trong hải sản mang lại giải pháp nhanh chóng, chi phí thấp để ngăn ngừa bệnh tật do thực phẩm gây ra.

Thử nghiệm nhanh mới về Vibrio parahaemolyticus trong hải sản mang lại giải pháp nhanh chóng, chi phí thấp, có khả năng ngăn chặn bùng phát dịch bệnh do thực phẩm
Các nhà khoa học đã phát triển một phương pháp xét nghiệm tại điểm chăm sóc (POCT) mang tính đột phá nhằm phát hiện Vibrio parahaemolyticus – vi khuẩn nguy hiểm gây ra nhiều bệnh truyền qua thực phẩm. Phương pháp này kết hợp kỹ thuật khuếch đại polymerase tái tổ hợp (RPA) với hệ thống CRISPR/Cas12a và dải thử sắc ký miễn dịch (ICS), tạo ra một giải pháp phát hiện mầm bệnh đơn giản, chi phí thấp và dễ quan sát, cho phép xác định nhanh sự hiện diện của vi khuẩn trong hải sản. Đây được xem là bước tiến quan trọng trong việc tăng cường an toàn thực phẩm và bảo vệ sức khỏe cộng đồng.
Vibrio parahaemolyticus là vi khuẩn gram âm, ưa mặn, phân bố rộng rãi trong môi trường biển và là một trong những tác nhân chính gây hoại tử gan tụy cấp tính (AHPND hay hội chứng chết sớm) trong nuôi trồng thủy sản. Vi khuẩn này cũng gây nguy cơ lớn đối với sức khỏe con người khi tiêu thụ hải sản sống hoặc chưa được nấu chín, dẫn đến ngộ độc thực phẩm. Khả năng bám dính mạnh trên bề mặt hải sản, tốc độ lây lan nhanh và tiềm năng gây dịch bệnh khiến việc phát hiện sớm trở nên đặc biệt quan trọng. Tuy nhiên, các phương pháp phát hiện truyền thống dựa trên phân lập, nuôi cấy và định danh sinh hóa hiện nay thường tốn nhiều thời gian, không đáp ứng được yêu cầu xét nghiệm nhanh tại điểm chăm sóc.
Tuy nhiên, các nhà khoa học từ Viện Khoa học Nông nghiệp Thượng Hải đã tiết lộ một nền tảng phát hiện mới có thể xác định Vibrio parahaemolyticus trong vòng 30 phút.
Nền tảng này sử dụng phương pháp kết hợp bao gồm khuếch đại polymerase tái tổ hợp (RPA), hệ thống CRISPR/Cas12a và dải thử nghiệm sắc ký miễn dịch (ICS). Nó đặc biệt nhắm vào gen tlh của V. parahaemolyticus, tạo điều kiện thuận lợi cho việc phát hiện độ nhạy. Quy trình bắt đầu bằng việc trích xuất DNA vi khuẩn từ mẫu hải sản, sau đó là RPA để khuếch đại. Sau đó, hệ thống CRISPR/Cas12a sẽ xác định và phân tách chính xác gen mục tiêu, với ICS cung cấp xác nhận trực quan về sự hiện diện của vi khuẩn. Phương pháp này đạt giới hạn phát hiện là 2,5×102 fg/µL đối với DNA plasmid và 1,4×102 CFU/mL đối với vi khuẩn. Nó có thể phát hiện V. parahaemolyticus trong sashimi cá hồi ở nồng độ thấp tới 154 CFU mỗi gam mà không cần làm giàu mẫu.
Bước đột phá này khắc phục những hạn chế của các phương pháp nuôi truyền thống, mang lại cách tiếp cận nhanh hơn, dễ tiếp cận hơn để giám sát an toàn hải sản. Sự đổi mới này có thể làm giảm đáng kể nguy cơ mắc bệnh do thực phẩm từ hải sản.
Tiến sĩ Haijuan Zeng, tác giả và lãnh đạo Viện Nghiên cứu Công nghệ sinh học tại Viện Nghiên cứu Công nghệ sinh học tại Đại học New York cho biết : “Nền tảng phát hiện cải tiến của chúng tôi thể hiện sự tiến bộ đáng kể trong việc phát hiện nhanh chóng và nhạy cảm Vibrio parahaemolyticus, chứng tỏ nó đặc biệt có giá trị trong việc đảm bảo an toàn hải sản và ngăn ngừa khủng hoảng sức khỏe cộng đồng”. Viện Khoa học Nông nghiệp Thượng Hải.
Phương pháp mới này có thể mang đến một giải pháp nhanh chóng, tiết kiệm chi phí để sử dụng trong quá trình xử lý thực phẩm hoặc tại các điểm bán hàng, rút ngắn khung thời gian phát hiện và có khả năng ngăn chặn sự bùng phát bệnh do thực phẩm trước khi sản phẩm bị ô nhiễm đến tay người tiêu dùng.
Theo Responsible Seafood Advocate
Biên dịch: Nguyễn Thị Quyên – Bình Minh Capital
Xem thêm:
- Đâu Là Giải Pháp Thay Thế Khả Thi Cho Việc Cắt Bỏ Cuống Mắt Tôm?
- Phục Hồi Hỗn Hợp’: Rabobank Dự Báo Ngành Tôm Sẽ Tăng Trưởng Chậm Vào Năm 2024, Đối Mặt Với Nhiều Thách Thức Thị Trường Toàn Cầu
- Dầu Cọ Thay Thế Dầu Cá Trong Thức Ăn Cho Cá Rô Phi
English